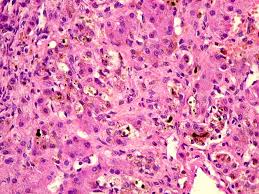

BILIRRUBINAS DIRETA E INDIRETA
Após 120 dias de vida média, os glóbulos vermelhos “envelhecem” pelo esgotamento das enzimas eritrocitárias. Sendo uma célula anucleada não renova o seu estoque de enzimas e, portanto, o metabolismo da glicose diminui com redução na formação de ATP. Há, em conseqüência, modificação da membrana e o glóbulo vermelho é retido pelo macrófago do sistema retículo endotelial (baço, fígado e medula óssea) onde é destruído. O ferro retorna ao plasma e se liga à tranferrina.
Após 120 dias de vida média, os glóbulos vermelhos “envelhecem” pelo esgotamento das enzimas eritrocitárias. Sendo uma célula anucleada não renova o seu estoque de enzimas e, portanto, o metabolismo da glicose diminui com redução na formação de ATP. Há, em conseqüência, modificação da membrana e o glóbulo vermelho é retido pelo macrófago do sistema retículo endotelial (baço, fígado e medula óssea) onde é destruído. O ferro retorna ao plasma e se liga à tranferrina.
A globina é degradada em seus aminoácidos com posterior reutilização. A protoporfirina IX é clivada para formar biliverdina que, por sua vez, é reduzida à bilirrubina, um tetrapirrol insolúvel em água.
A bilirrubina não-conjugada ou bilirrubina indireta produzida no Sistema Retículo Endotelial é apolar e insolúvel em água e é transportada para o fígado via corrente circulatória ligada de maneira firme mas reversível, à albumina.
A bilirrubina isolada da albumina entra na célula hepática e, uma vez no citoplasma, se associa às proteínas Y e Z – sendo a primeira (Y) a principal transportadora do catíon da bilirrubina orgânica.
O processo de conjugação transforma a molécula não-polar da bilirrubina em uma mistura polar/não-polar que atravessa as membranas celulares.
Este derivado conjugado, solúvel em água, é excretado do hepatócito na forma de bile e constitui um dos pigmentos biliares. Devido a solubilidade em água, a bilirrubina conjugada é encontrada, em pequenas quantidades tanto no plasma como na urina. A excreção da bilirrubina é a fase limitante do processo.
A bilirrubina conjugada é pouco absorvida pela mucosa intestinal. No íleo terminal e intestino grosso, o diglicuronídio da bilirrubina é hidrolisado para formar bilirrubina livre e ácido glicurônico. No cólon, a bilirrubina livre é reduzida pela b-glicuronidase para formar urobilinogênios. Estes compostos são oxidados com formação de urobilinas e estercobilinas. Quase toda a bilirrubina formada diariamente no adulto normal (250 a 300 mg/d) é eliminada nas fezes enquanto uma pequena quantidade é excretada na urina.
A icterícia é a pigmentação amarela de pele, esclerótica e membranas mucosas, resultante da hiperbilirrubinemia. Um exame laboratorial de urina pode indicar um aumento da bilirrubina, o que significa que o indivíduo pode ter icterícia.
O exame é feito em laboratório, analisando um pouco da urina do indivíduo por alguns minutos, e não é preciso nenhuma preparação para realizar o exame.
O uso de alguns medicamentos como os nitratos, vitamina C e outros, pode alterar os resultados da análise, assim como deixar a urina exposta à luz solar.
A icterícia deixa a pele e mucosas com uma cor amarelada típica, esse exame serve para confirmar o diagnóstico.
Um exame laboratorial de urina pode indicar um aumento da bilirrubina, o que significa que o indivíduo pode ter icterícia.
O exame é feito em laboratório, analisando um pouco da urina do indivíduo por alguns minutos, e não é preciso nenhuma preparação para realizar o exame.
O uso de alguns medicamentos como os nitratos, vitamina C e outros, pode alterar os resultados da análise, assim como deixar a urina exposta à luz solar.
A icterícia deixa a pele e mucosas com uma cor amarelada típica, esse exame serve para confirmar o diagnóstico.
O processo de conjugação transforma a molécula não-polar da bilirrubina em uma mistura polar/não-polar que atravessa as membranas celulares.
Bilirrubina total e frações
Este teste é usado para medir os níveis séricos de bilirrubina, o pigmento predominante na bile. A bilirrubina é o principal produto do catabolismo da hemoglobina. As medições da bilirrubina sérica são especialmente significativas em recém-nascidos, uma vez que a bilirrubina indireta ou não-conjugada elevada pode acumular no cérebro, causando comprometimentos irreparáveis.
 Hiperbilirrubinemia predominantemente não-conjugada (indireta).
Hiperbilirrubinemia predominantemente não-conjugada (indireta).
A icterícia pré –hepática resulta da presença excessiva de bilirrubina não-conjugada no sangue circulante, provocando maior oferta ao hepatócito que não consegue captá-la em velocidade compatível com sua produção, ocasionando icterícia. A bilirrubina não-conjugada não é hidrossolúvel e está ligada à albumina não conseguindo ultrapassar a barreira renal e, portanto, não é excretada na urina. Entretanto, dissolve-se rapidamente em ambientes ricos em lipídios e atravessa a barreira hemato-encefálica. Quando em níveis elevados tende a depositar no tecido nervoso levando ao risco de lesão neurológica provocando a síndrome de kernicterus (do alemão: amarelo nuclear). A bilirrubina conjugada não sendo lipossolúvel, não causa kernicterus.
Icterícia fisiológica do recém-nascido. Como existe pouca ou nenhuma atividade da UDPGT no fígado do feto, há uma habilidade muito l imitada para a conjugação da bilirrubina. Por isso, a bilirrubina isolada é transferida atravésda placenta à circulação materna, onde é processada pelo fígado da mãe. Em crianças nascidas a termo as concentrações de bilirrubina no soro estão ao redor de 4 -6 mg/dL durante as primeiras 48 h de vida extra -uterina, voltando, es pontaneamente, ao normal em 7-10 dias. A incidência da hiperbilirrubinemia é muito maior entre prematuros e neonatos de baixo peso corporal. Crianças nascidas prematuramente atingem uma concentração média de bilirrubina no soro entre 10-12 mg/dL, entre 5 e 6 dias de vida. As causas da hiperbilirrubinemia neonatal são: (a) produção excessiva de bilirrubina, (b) transporte insuficiente de bilirrubina, (c) formação deficiente de bilirrubina, (d) acoplamento inapropriado d e bilirrubina, (e) circulação êntero -hepática. (f) eritropoiese não-efetiva (ex.: anemia perniciosa). A hiperbilirrubinemia é comumente encontrada em neonatos podendo ser considerada na maioria dos casos, fisiológica. Contudo, a bilirrubina pode ser tóxica ao sistema nervoso central, merecendo cuidados, pois existe possibilidade de sua origem ser patológica.
Icterícia hemolítica (destruição excessiva de hemácias circulantes). Pode ser devida à exposição a produtos químicos, reações hemolíticas antígeno-anticorpo, enfermidades como o câncer e drogas. Em adultos o teor de bilirrubina não-conjugada dificilmente ultrapassa 5mg/dL. Em neonatos, o excesso de hemólise é provocado principalmente por excesso de hemólise (como a doença hemolítica causada por sistema ABO ou Rh incompatível, esferocitose hereditária, deficiência de glicose 6 -fosfato desidrogenase e outras enzimopatias eritrocitárias) e que podem atingir concentrações acima de 20 mg/dL de bilirrubina não-conjugada. Hiperbilirrubinemia predominantemente conjugada (direta).
Hiperbilirrubinemia predominantemente conjugada (direta).
Indica um comprometimento na captação, no armazenamento ou na excreção da bilirrubina. Assim, tanto a bilirrubina conjugada como a não-conjugada são retidas, aparecendo em variadas concentrações no soro.
Colestase intrahepática. Quando qualquer porção da árvore biliar está bloqueada ou anormalmente permeável, à passagem da bilirrubina e de todos os o utros componentes da bile é reduzida; assim, estas substâncias são retidas. Deste modo, as concentrações plasmáticas da bilirrubina conjugada, colesterol, g-glutamil-transferase (g-GT), fosfatase alcalina (FA) e ácidos biliares estão aumentadas. Além disso, a obstrução da árvore biliar também promove um aumento na síntese das enzimas g-GT e FA elevando seus teores no sangue.
Colestase induzida por drogas e hormônios esteroides e, ocasionalmente, a hepatite alcoólica e hepatite viral aguda são causas de colestase intra-hepática. Nestes casos, os canalículos biliares e ductos de pequeno calibre são afetados, enquanto os canais de maior diâmetro permanecem normais. Níveis persistentemente altos de bilirrubinemia indicam evolução desfavorável. A evidência d e lesão e disfunção hepatobiliar é geralmente proeminente e inclui elevação das transaminases, tempo de protrombina prolongado e hipoalbuminemia. As causas mais comuns são:
Doença hepatocelular aguda (hepatite viral), cirrose biliar primária (principalmnete em mulheres com 40-60 anos e associada com esteatorréia, xantomatose e hipertensão portal) e colangite esclerosante (desordem rara caracterizada por inflamação do trato biliar que leva à fibrose).
Não associada com lesão hepática: colestase pós-operatória, nutrição parenteral, gravidez, esteróides e infecções sistêmicas.
Obstrução biliar extra hepática, completa ou parcial dos ductos biliares, produz concentrações séricas aumentadas de bilirrubina conjugada e s ão observadas no carcinoma da cabeça de pâncreas, tumores dos ductos biliares ou ampola de Vater; coledocolitíase; fibrose de cabeça de pâncreas, coágulos sangüíneos, anomalias congênitas, pancreatites crônicas e processos inflamatórios na vizinhança, retenção de cálculos biliares e estenose do ducto comum secundário à lesão ductal após cirurgia.
Colestase induzida por drogas, pode ser induzida pelos fenotiazínicos, anticoncepcionais orais e a metiltestosterona. A eosinofilia pode acompanhar este tipo d e icterícia.
Hiperbilirrubinemia predominantemente não-conjugada (indireta).
A icterícia pré –hepática resulta da presença excessiva de bilirrubina não-conjugada no sangue circulante, provocando maior oferta ao hepatócito que não consegue captá-la em velocidade compatível com sua produção, ocasionando icterícia. A bilirrubina não-conjugada não é hidrossolúvel e está ligada à albumina não conseguindo ultrapassar a barreira renal e, portanto, não é excretada na urina. Entretanto, dissolve-se rapidamente em ambientes ricos em lipídios e atravessa a barreira hemato-encefálica. Quando em níveis elevados tende a depositar no tecido nervoso levando ao risco de lesão neurológica provocando a síndrome de kernicterus (do alemão: amarelo nuclear). A bilirrubina conjugada não sendo lipossolúvel, não causa kernicterus.
Icterícia fisiológica do recém-nascido. Como existe pouca ou nenhuma atividade da UDPGT no fígado do feto, há uma habilidade muito l imitada para a conjugação da bilirrubina. Por isso, a bilirrubina isolada é transferida atravésda placenta à circulação materna, onde é processada pelo fígado da mãe. Em crianças nascidas a termo as concentrações de bilirrubina no soro estão ao redor de 4 -6 mg/dL durante as primeiras 48 h de vida extra -uterina, voltando, es pontaneamente, ao normal em 7-10 dias. A incidência da hiperbilirrubinemia é muito maior entre prematuros e neonatos de baixo peso corporal. Crianças nascidas prematuramente atingem uma concentração média de bilirrubina no soro entre 10-12 mg/dL, entre 5 e 6 dias de vida. As causas da hiperbilirrubinemia neonatal são: (a) produção excessiva de bilirrubina, (b) transporte insuficiente de bilirrubina, (c) formação deficiente de bilirrubina, (d) acoplamento inapropriado d e bilirrubina, (e) circulação êntero -hepática. (f) eritropoiese não-efetiva (ex.: anemia perniciosa). A hiperbilirrubinemia é comumente encontrada em neonatos podendo ser considerada na maioria dos casos, fisiológica. Contudo, a bilirrubina pode ser tóxica ao sistema nervoso central, merecendo cuidados, pois existe possibilidade de sua origem ser patológica.
Icterícia hemolítica (destruição excessiva de hemácias circulantes). Pode ser devida à exposição a produtos químicos, reações hemolíticas antígeno-anticorpo, enfermidades como o câncer e drogas. Em adultos o teor de bilirrubina não-conjugada dificilmente ultrapassa 5mg/dL. Em neonatos, o excesso de hemólise é provocado principalmente por excesso de hemólise (como a doença hemolítica causada por sistema ABO ou Rh incompatível, esferocitose hereditária, deficiência de glicose 6 -fosfato desidrogenase e outras enzimopatias eritrocitárias) e que podem atingir concentrações acima de 20 mg/dL de bilirrubina não-conjugada.
Hiperbilirrubinemia predominantemente conjugada (direta).
Indica um comprometimento na captação, no armazenamento ou na excreção da bilirrubina. Assim, tanto a bilirrubina conjugada como a não-conjugada são retidas, aparecendo em variadas concentrações no soro.
Colestase intrahepática. Quando qualquer porção da árvore biliar está bloqueada ou anormalmente permeável, à passagem da bilirrubina e de todos os o utros componentes da bile é reduzida; assim, estas substâncias são retidas. Deste modo, as concentrações plasmáticas da bilirrubina conjugada, colesterol, g-glutamil-transferase (g-GT), fosfatase alcalina (FA) e ácidos biliares estão aumentadas. Além disso, a obstrução da árvore biliar também promove um aumento na síntese das enzimas g-GT e FA elevando seus teores no sangue.
Colestase induzida por drogas e hormônios esteroides e, ocasionalmente, a hepatite alcoólica e hepatite viral aguda são causas de colestase intra-hepática. Nestes casos, os canalículos biliares e ductos de pequeno calibre são afetados, enquanto os canais de maior diâmetro permanecem normais. Níveis persistentemente altos de bilirrubinemia indicam evolução desfavorável. A evidência d e lesão e disfunção hepatobiliar é geralmente proeminente e inclui elevação das transaminases, tempo de protrombina prolongado e hipoalbuminemia. As causas mais comuns são:
Doença hepatocelular aguda (hepatite viral), cirrose biliar primária (principalmnete em mulheres com 40-60 anos e associada com esteatorréia, xantomatose e hipertensão portal) e colangite esclerosante (desordem rara caracterizada por inflamação do trato biliar que leva à fibrose).
Não associada com lesão hepática: colestase pós-operatória, nutrição parenteral, gravidez, esteróides e infecções sistêmicas.
Obstrução biliar extra hepática, completa ou parcial dos ductos biliares, produz concentrações séricas aumentadas de bilirrubina conjugada e s ão observadas no carcinoma da cabeça de pâncreas, tumores dos ductos biliares ou ampola de Vater; coledocolitíase; fibrose de cabeça de pâncreas, coágulos sangüíneos, anomalias congênitas, pancreatites crônicas e processos inflamatórios na vizinhança, retenção de cálculos biliares e estenose do ducto comum secundário à lesão ductal após cirurgia.
Colestase induzida por drogas, pode ser induzida pelos fenotiazínicos, anticoncepcionais orais e a metiltestosterona. A eosinofilia pode acompanhar este tipo d e icterícia.
Hiperbilirrubinemia
Hiperbilirrubinemia ou querníctero é uma doença causada pelo excesso de bilirrubina na corrente sanguínea que se acumula no cérebro podendo causar danos cerebrais. Esta doença atinge em maior número os bebês recém-nascidos prematuros ou os que estão muito doentes e é caracterizado pela coloração amarelada da pele, olhos e fezes do bebê.
A bilirrubina é o resultado de uma alteração normal que acontece com as células sanguíneas sendo expelidas normalmente através da bilis. No caso das crianças que desenvolvem esta doença, o problema está no organismo não conseguir eliminar a bilirrubina e ela vai acumulando-se podendo gerar complicações mais graves.
Nos casos mais graves os bebês com hiperbilirrubinemia devem ser expostos a uma luz de bilirrubina, como forma de tratamento. Esta doença surge logo nos primeiros dias de vida do bebê, e é observada ainda quando eles estão no hospital após seu nascimento.
Quando o bebê não é devidamente tratado podem surgir complicações como sonolência excessiva, vômitos, convulsões, atraso mental, surdez, paralisia dos olhos voltados para cima e arqueamento do pescoço e das costas para trás e em alguns casos pode ser fatal.
Hiperbilirrubinemia ou querníctero é uma doença causada pelo excesso de bilirrubina na corrente sanguínea que se acumula no cérebro podendo causar danos cerebrais. Esta doença atinge em maior número os bebês recém-nascidos prematuros ou os que estão muito doentes e é caracterizado pela coloração amarelada da pele, olhos e fezes do bebê.
A bilirrubina é o resultado de uma alteração normal que acontece com as células sanguíneas sendo expelidas normalmente através da bilis. No caso das crianças que desenvolvem esta doença, o problema está no organismo não conseguir eliminar a bilirrubina e ela vai acumulando-se podendo gerar complicações mais graves.
Nos casos mais graves os bebês com hiperbilirrubinemia devem ser expostos a uma luz de bilirrubina, como forma de tratamento. Esta doença surge logo nos primeiros dias de vida do bebê, e é observada ainda quando eles estão no hospital após seu nascimento.
Quando o bebê não é devidamente tratado podem surgir complicações como sonolência excessiva, vômitos, convulsões, atraso mental, surdez, paralisia dos olhos voltados para cima e arqueamento do pescoço e das costas para trás e em alguns casos pode ser fatal.
Hiperbilirrubinemia do Recém-Nascido
A hiperbilirrubinemia do recém-nascido é uma doença que surge logo nos primeiros dias de vida do bebê sendo causada pelo acúmulo de bilirrubina no sangue, deixando o bebê amarelado.
Esta doença deve ser tratada rapidamente para que a quantidade de bilirrubina no sangue não seja muito elevada, o que pode causar complicações graves como surdez, convulsões e morte.
Não se sabe exatamente porque a doença surge, mas em alguns casos suspeita-se que ela possa ser causada pelo leite materno. Neste caso, o bebê deve ser alimentado com um leite adaptado até ficar curado, podendo voltar ao leite materno a seguir. Em geral a hiperbilirrubinemia desaparece na primeira semana de vida do bebê e não causa mais problemas.
Somente nos casos em que a bilirrubina aumenta grandemente é que é necessário o tratamento com fototerapia, que consiste em deixar o bebê exposto à uma luz de bilirrubina durante algumas horas todos os dias.
A luz penetra na pele estimulando a eliminação da bilirrubina, fazendo com que a icterícea (amarelão) vá desaparecendo.
Quando a bilirrubina coemça a acumular-se no cérebro ela é chamada de querníctero.
A hiperbilirrubinemia do recém-nascido é uma doença que surge logo nos primeiros dias de vida do bebê sendo causada pelo acúmulo de bilirrubina no sangue, deixando o bebê amarelado.
Esta doença deve ser tratada rapidamente para que a quantidade de bilirrubina no sangue não seja muito elevada, o que pode causar complicações graves como surdez, convulsões e morte.
Não se sabe exatamente porque a doença surge, mas em alguns casos suspeita-se que ela possa ser causada pelo leite materno. Neste caso, o bebê deve ser alimentado com um leite adaptado até ficar curado, podendo voltar ao leite materno a seguir. Em geral a hiperbilirrubinemia desaparece na primeira semana de vida do bebê e não causa mais problemas.
Somente nos casos em que a bilirrubina aumenta grandemente é que é necessário o tratamento com fototerapia, que consiste em deixar o bebê exposto à uma luz de bilirrubina durante algumas horas todos os dias.
A luz penetra na pele estimulando a eliminação da bilirrubina, fazendo com que a icterícea (amarelão) vá desaparecendo.
Quando a bilirrubina coemça a acumular-se no cérebro ela é chamada de querníctero.
Dosagem de Bilirrubina
Aluna: Yasmin Kao
A bilirrubina é um produto resultante do metabolismo do heme responsável pela cor amarelada da pele e mucosas quando em excesso no sangue; fato a qual denominamos de icterícia.
O processo de síntese e metabolismo da bilirrubina, para fins didáticos, pode ser dividido em quatro etapas; captação, transporte, conjugação e excreção. A primeira fase se refere à captação de eritrócitos pelo baço, fígado e medula óssea os quais são os órgãos responsáveis pela degradação destas células quando atingem o ciclo de 120 dias de vida, entretanto umas partes consideráveis da bilirrubina provem da degradação de hemácia no baço (cerca de 70%-80%).
O processo se inicia com a clivagem oxidativa entre os anéis A e B da porfirina do heme pela heme-oxigenase formando biliverdina a qual sofrerá redução da sua ponte metenil central ( entre os anéis C e D) resultando na bilirrubina, esta é caracterizada como bilirrubina não-conjugada ou indireta, pois não sofreu reação conformacional para ser excretada.
A segunda e terceira etapas começam quando a bilirrubina plasmática é associada com a albumina (proteína plasmática de maior quantidade no sangue) e transportada ao fígado desligando-se para formar um complexo com as proteínas Y e Z e, posteriormente, com a ligandina a qual carreará para o retículo endoplasmático liso; nele a bilirrubina indireta sofrerá um processo de hidrofilização já que inicialmente é lipossolúvel através de uma esterificação dos dois grupos laterais propianato com o ácido glucurônico resultando nos compostos; monoglucorídeo Bb e diglucoronídeo Bb pela enzima uridina disfosfoglucuranil transferase (UDPGT), a partir de então, a bilirrubina indireta passa-se a bilirrubina direta ou conjugada.
A fase de excreção caracteriza-se quando a bilirrubina conjugada é resguardada na vesícula biliar e, através do estímulo da colecistoquinina, é excretada para o duodeno atravessando o intestino delgado sem modificações. Quando chega às porções do ceco e colo do intestino grosso sofre ação da b-glucuronidase (enzima bacteriana), hidrolisando-a e transformando-a em urobilinogênio que pode ser ou não reabsorvido pelo sistema enterohepático para formar bilirrubina novamente ou metabolizado e eliminado pelo rim em forma de urobilina, porém é a maior parte eliminada nas fezes na forma de estercobilinogênio ou estercobilinogênio fecal sendo este o responsável pela cor marrom-avermelhada delas.
A bilirrubina tem relação intrínseca com a função hepática, pois, além de ser nos hepatócitos em que a bilirrubina indireta é transformada em bilirrubina conjugada, funciona como indicadoras bioquímicas para varias patologias relacionadas com a dosagem da bilirrubina no sangue e também como indicador do funcionamento normal do fígado. A mais conhecida delas é a icterícia em que uma das causas é o aumento da bilirrubina não-conjugada devido ao excesso de eritrócitos senescentes no sangue. Anemia hemolítica cuja causa mais conhecida é a deficiência da enzima G6PD possui como uma dos sintomas a icterícia causado pelo acúmulo de bilirrubina no sangue devido à insuficiência hepática de metabolizar o excesso de eritrócitos destruídos. Outros problemas oriundo da hiperbilirrubinemia são a obstrução dos ductos biliares impedindo a secreção de sais biliares à porção duodênica do intestino delgado e Kernicterus doença caracterizada pela impregnação do SNC por bilirrubina não conjugada.
À maneira geral, a bilirrubina serve para verificar o estado geral do fígado e observar sinais de doença hepática, tais como hepatite ou cirrose, ou os efeitos de medicamentos que podem prejudicar o órgão; Diagnosticar as condições que causam o aumento da destruição das hemácias, como anemia hemolítica ou doença hemolítica do recém-nascido; Verificar bloqueios dos ductos biliares - Isto pode ocorrer se cálculos biliares, tumores do pâncreas, ou outras condições que podem estar presentes- e diagnosticar e acompanhar tratamento de icterícias neonatais.
O diagnóstico laboratorial bioquímico do sangue através da dosagem de proteínas séricas do plasma, alguns exemplos;
- TGO e TGP
- Fosfatase alcalina
- Tempo de Protrombina
- Albumina Sérica
- Técnica de dosagem de bilirrubina
Técnica colorimétrica de determinação de bilirrubina através de soro ou plasma, apenas realizável in vitro. Foi feita a dosagem para bilirrubina total e bilirrubina direta; o fator (F) de determinação da curva padrão já tinha sido calculado, por isso não foi feito a curva de calibração para este teste.
- Metodologia
Usaram-se tubos de deposito do plasma (amostra), ao todo foram 03 amostras, e dos reagentes para o branco, tais reagentes foram; nitrito de sódio, Reagente sulfanílico, Água destilada e Solução aceleradora. Após a identificação dos tubos em BT (Bilirrubina Total), BD (Bilirrubina Direta) e B (Branco), depositaram-se 2 gotas do Nitrito de sódio nos tubos BT e BD, 4 gotas do reagente sulfinílico no B e nos tubos restantes, de água destilada foi pepitada 4 mL somente no B e no BD sendo a solução aceleradora somente no BT e, por último, a amostra. Agitou-se para misturar os substratos e deixou-se repousar por 3 minutos antes de fazer a leitura.
Teve-se o cuidado de não encostar a gota na lateral do vidro do tubo e de ter atenção na ordem de depósito dos reagentes foi para evitar a formação do composto diazo-reagente o qual poderia provocar uma diminuição dos resultados, induzindo a resultados falsamente diminuídos.
Foi utilizada a técnica de dosagem Macro, pois a Micro é válida somente para dosagens em amostras com bilirrubinas elevadas.
A leitura foi realizada no espectrofotômetro semi-automatizado a 530nm ou filtro verde para a quantificação do Branco e das amostras. Não se observou nenhuma mudança de cor e aspecto do material antes ou após a dosagem semi-quantitativa.
- Resultados
Seguindo o protocolo do laboratório DOLES cujos parâmetros foram BD até 0,4mg/dL e BT até 1,2 mg/dL. Para todas as amostras, os níveis de bilirrubinas não ultrapassaram a faixa considerada normal pelo procedimento do laboratório DOLES.
- Conclusão
A técnica de dosagem de bilirrubina é um procedimento sensível, há de ter treino e atenção do biomédico, pois qualquer confusão na ordem dos reagentes ou desleixo no momento de alguma etapa de colocação do reagente na amostra pode levar todo o trabalho a ser invalidado. É um procedimento quantitativo já que, no final, usa-se o espectrofotômetro e o desenho de uma curva absorbância-concentração e eficaz para diagnóstico ou validação de prognóstico cuja suspeita seja alguma disfunção hepática ou doença provinda desta.
Nenhum comentário:
Postar um comentário